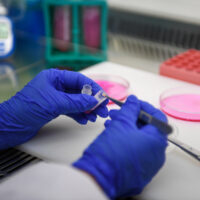

Our Biobanking Model
Gamete & skin sample cryopreservation and regeneration
At the UK National Livestock Biobank, our biobanking model is built upon gamete storage (sperm, egg & embryo) and skin sample cryopreservation & regeneration. For indefinite whole genetic profile conservation of livestock breeds & species
What Is Biobanking?
A biobank is a collection of biological and genetic material. Biobanks can have several functions, including to aid in health & disease.
The UK National Livestock Biobank aims to provide a repository of genetic & reproductive material for livestock breeds & species, to provide them with reproductive resilience against future unknowns and population challenges.

The Biobanking Process

1. Skin & gamete sample submitted
2. Genetic Preservation

3. Cell Culture

4. Indefinite Storage
We hope to collect across all species, all genders and all age categories to create a systematic banking and a central database for the cataloging of banked genetics
The Power Of Skin Samples
At the National Livestock Biobank, we believe the future is skin.
Gamete Sample Storage
Alongside the preservation of skin samples, the UK National Livestock Biobank also provides for gamete sample storage. this includes frozen semen, embryos and eggs. This reproductive sample repository can be used to collate on farm semen collections to a central, cataloged system, enabling the capture of reproductive resources that could prove vital to future farming systems.

Skin Sample Applications Once Preserved

Cryopreservation

Genetic Replication

Artificial Reproduction

Genomic Passports

The Future

Genetic Replication For Herd Resilience
- Preserved skin samples could be used for genetic replication
- Restoration of lost genetic sets
- Re-introduction of genetic diversity to closed populations
- Continued presence of key production lines beyond the natural lifespan
Artificial Reproduction
- Sperm and egg cells produced via induced pluripotent stemcell technology


Genomic Passports & Product Traceability
- A likely future requirement for the food sector Samples submitted for livestock
- biobanking can also be used for DNA profiles & genomic passports